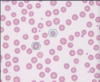
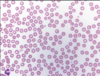
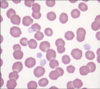
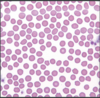
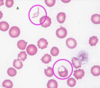
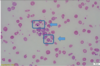

Describe the procedure and anatomical location for a caudal; yhigh epidural in a cow ?

High epidural in a cow
(18G, 1.5inch and 5-10ml syringe; 4-6ml 2% lignocaine)
High caudal epidural = Sacrococcygeal space
- Locate injection site by pumping the tail and palpating the joint
- most obvious articulation caudal to the sacrum
- place needle perpendicular to the skin and slightly cranial.
- needle peirces through the ligamentum flavum
- desensitizes S2,S3, S4 and S5
- Aspirate before injecting (real risk of injecting the venous sinus - pressence of blood).
- listen close to the hub of the needle (without syringe attached) one the needle enters the epidural air space air may be heard being sucked in
- hanging drop technique (difficult to achieve)
- place air into the syringe, if correctly positioned should advance very easily
Equipment
- Clippers and surgical scrub - chlorohexidine and 70% alcohol solution.
- 18G needle 1.5 inch
- 5-10ml syringe
- 4-6ml 2% lignocaine

What are the indications for an epidural ?

Indicaions for an epidural
( the most common anaesthetic carried out in cattle)
- Obstetric manipulations
- surgical procedures of the tail, perineum, anus, rectum and caudal aspects of the thighs

Describe the advantages and disadvantages of carrying out an epidural in cattle ?

Epidural in cattle
Advantages
- cheap only 4-6ml lignocaine 2%
- easy to perform
- cheap
Diasadvantages
- it may be difficult to locate landmarks in fat animals
- injecting to high of a dose could potentially result in ataxia and / or recumbancy.
- entry of infection (not an aseptic technique) can lead to permanent paralysis of the tail and and constant soiling of the perineal area.

How can we assess our epidural was effective ?

Was our epidural effective
- tail should be notably floppy
- sensory inervation is lost from the anus may observe relaxation of the anal sphincter and peripheral anus may balloon
- tenesmus will be relieved
- pricking, noting sensory innervation is lost from the anus, vulva and perineum

Describe the procedure of a caudal low point epidural ?

Low point caudal epidural
Equipment
- 18G needle, 1.5”
- 5-10ml syringe
- 4-6ml 2% lignocaine
Procedure
- Clip and scrub thoroughly with chlorohexidine
- ensure animal is adequately restrained
- Pump the tail to identify anatomical location
- Location for injection is between the first and second coccygeal vertebrae
- remove syringe from needle place quickly perpendicular to the skin and slightly cranially
- place air in syringe with lignocaine prior to reatachment
- aspirate to ensure you do not inject into the venous sinus.
- if correctly positioned should be able to easily push plunger (no resistance is felt)

Describe the procedure for carrying out an inverted L-block ?
Procedure for an inverted L block
Equipment
-Chlorhexidine scrub and 70% alcohol solution
- clippers
- 18G needle 1.5”
- 20ml syringe or vaccinating gun (5ml)
- 80-100ml 2% lignocaine
Method
- clip and scrub
- deposit a bleb of the anaesthetic solution in the corner of the inverted L, just caudal to the last rib + ventral to the transverse process of the first lumbar vertebrae
- advance full length of needle in a caudal direction, while injecting small amounts of solution
- move along a line just ventral to the transverse processes of the lumbar vertebrae
- continue injecting along the dorsal branch of the inverted L until the desired length is reached
- caudal to the last rib
Return to the staring point and continue this process along the transverse line
- to achieve infiltration of deeper tissues
- this time inject parallel to the skin along the previously injected ‘L’

Describe the indications for a inverted L block ?
Indications for an inverted L block ?
Anaesthesia of the paralumbar fossa and abdominal wall;
- surgery of the GIT tract
- caesarian operation
The spinal nerves innervating skin and muscles of the flank run in a slightly caudo-ventral direction.
- Linear L block two infiltrations of the entire abdominal wall (anterior to and above +cranial)
Describe the advantages and disadvantages to a inverted L block in cattle ?
Inverted L block
Advantage
- simple to perform
- does not interfer with walking
- deposition of anaesthetic solution away from incision site
- no oedema / haematoma
- no scoliosis
Disadvantage
- requires a large amount of anaesthetic solution (cost + toxicity)
- incomplete analgesia and muscle relaxation of the deeper layers of the abdominal wall (especially in obese animals)

Describe the process of a paravertebral block ?

Paravertebral block
(desensitizes T13, L1 and L2)
Ensure every time you insert the needle there is a tail jack
Equipment
- clippers and chlorohexidine scrup
- markers
- gloves
- 18G 1.5” needle and a 10-20ml syringe
- 18G spinal needle, 20ml syringe
- 45ml 2% lignocaine
Location
The points of injection will be 5-6cm away from the dorsal midline (metchbox)
- block lumbar nerve 2 caudal edge of L2
- block lumbar nerve one caudal edge of L1
- block Thoracic nerve 13 cranial edge of L1
Method (Stage one; 5ml each site = 15ml)
- ensure restraint, clipping and scrub
- mark off the injection sites
- starting at L2 every time, as T13 is the least well tolerated
- first place a 2ml bleb of anaesthetic solution at each injection site with 18G 1.5” needle
- then redirect needle so that it is perpendicular to L2 and inject a further 3ml into the underlying fascia and muscle
(Stage two; 10ml each site = 30ml total)
- attach spinal needle and insert into desensitized area perpendicular to the transverse process
- inject small amounts of anaesthetic solution as the needle is advanced (prevents muscle spasm)
- when the needle hits the caudal edge of the vertebrae with- draw slightly and rdirect so the it walks off the edge of the transverse process
- perforates the intertransverse ligament
- (attempt to aspirate needle if correctly positioned this will not be possible).
- inject 10ml solution below the ligment
- repeat for all three injection sites
Remember to complete T13 last as this site is the least well tolerated by cows

Describe the indications for a paravertebral nerve block ?
Paravertebral nerve block
Anaesthesia of the paralumbra fossa and the abdominal wall.
- blocks T13, L1 and L2
- allows surgery of the GIT or a caesarian procedure to take place.

Describe the advantages and disadvantages of a paravertebral nerve block ?

Paravertebral nerve block
Advantages
- smaller doses
- wide uniform analgesia and muscle relaxation
- absence of local anaesthetic solution at the incison site
Disadvantages
- muscle spasm of the loin muscle
- scoliosis of the spine
- animal may be weak in the ipsilateral pelvic limb as well as ataxic on release
- may be difficult to identify landmarks in obese animals.

What should we assess to check our paravertebral block was successful ?

Paravertebral block
- skin sensation; needle prick within the paralumbar fossa
- scoliosis (relaxation of muscles along one side).
- increased heat of skin within the paralumbar fossa, compared to skin felt in other areas.

Provide the indication for a cornual nerve block and what structures are blocked ?

Cornual nerve block
A cornual nerve block is indicated; for dehorning and treating a horn related injury.
Structures blocked;
The horn and skin around the base of the horn is inervated by cornual branch of the ophthalmic division of the trigeminal nerve.
- this nerve emerges from the orbit and runs just below the frontal crest situated fairly superficially.

Describe your method for carrying out a cornual nerve block ?

Cornual nerve block
Equipment
- 18G 1.5” needle
- 10-20ml syringe
- 5-10ml 2% lignocaine
Method (Adequately restrain the animal in a halter)
- Draw an imaginary line between the lanteral canthus of the eye and the horn base (identify your land marks)
- clean injection site with chlorhexidine and alcohol scrub
- inject about half way between the lateral canthus and horn base or 2.5 cm below the horn base
- direct needle at a 30 degree angle towards the base of the horn and below the facial crest
- inject 5-10ml of solution in an arc just below the edge of the frontal bone.
- firmly message the injection site

Describe the process of haltering and tying up a cows head ?

Placing a halter on a cow
- lead rope should come out to the left
- the lead rope movable part should run under the cows jaw
Tying up
- place rope around top bar
- use the leverage of your pulley system prior to trying to move the cows head
- attempt a pull knot if possible.

Describe the advantages and disadvantages to an auriculopalpebral nerve block ?

Auriculopalpebral nerve block
Adavantages
- facilitates examination of the eye by abolishing the srong tone in the eyelids
- particularly the bottom eyelid
- removal of a foreign body or application of medications
Disadvantage
- no analgesia of the eye (only blocks motor function)
- only effectively blocks the lower eyelid, therefore may need to aditionally perform a line block of the upper eye lid.

Describe the indications for a auriculopalpebral nerve block and the structures blocked ?

Auriculopalpebral nerve block
Indication; Paralysis of the eyelids (particularly of the lower eyelid.
- allows for eye examination
- application of medications into the subconjunctiva or removal of a foreign body
Structures blocked
- Auriculopalpebral nerve (a branch of the facial nerve).
- runs from the base of the ear along the dorsal border of the zygomatic arch, past and ventral to the eye

Describe your method for a Auricularpalpebral nerve block in a cow ?

Auriculopalpebral nerve block in a cow ?
Materials
- chlorhexidine / alcohol swabs
- 18G 1” needle
- 10-20ml syringe
- 10-15ml 2% lignocaine
Method
- Identify landmarks - palpate the zygomatic arch half way between the lateral canthus of the eye and the ear base.
- Adequately restrain animal with a halter
- clip and clean injection site chlorhexidine / alcohol swab
- insert needle on the dorsal border of the zygomatic arch
- deposit 10-15ml of anaesthetic solution
- analgesia in about 10-15mins which last for about an hour.

Describe the indications, which structures are blocked when we carry out a Peterson’s eye block ?

Peterson’s eye block
Structures blocked (4 nerves),
- oculomotor
- trochlear
- abducens
- and trigeminal nerve
These nerves are responsible for the sensory and motor function of all structures of the eye, except the eyelids.
Indications
- surgical treatment of traumatic injuries and neoplastic lesions of the eyes and its associated structures
- removal of the eyeball.

Describe the advantages and disadvantages of carrying out a Peterson’s eye block ?

Peterson’s eye block
Advanatage
- safer and more effective than retrobulbar nerve block
- less comparable oedema and inflammation
Disadvantage
- requires greater technical skill
- complications = poor analgesia
- damage to the optic nerve or potential injection into the meninges of the optic nerve

Outline your method for carrying out a Peterson’s eye block ?

Peterson’s eye block
Equipment;
- chlorhexidine / alcohol swabs
- 20G 1” needle, 20ml syringe
- spinal needle
- 45-60ml 2% lignocaine
Method
- restrain and clean the surgical site chl swab
- identify landmark (needle placement) is the notch formed by the supraorbital process cranially, zygomatic arch ventrally and coronoid process of the mandible caudally.
- inject 5ml of anaesthetic into the notch (bleb)
- place spinal needle horizontal to the ground but slightly caudally until it hits the coronoid process of the mandible
- walk the needle of the coronoid process rostrally
- continue advancing until it hits the bony orbit of the eye
- draw back syringe to ensure you do not inject into the ventral maxillary artery
- -inject solution above, below and cranially to the area around the orbital foramen
- allow 10-15mins for solution to take effect
- assess through the menace response, blink reflex and pupillary light response

Describe how you could safely lift the hind leg of a cow in stocks ?

Pulley system for lifting the hind leg of a cow.
(start by ensuring cow is safe through placement of a support strap)
- saddle over the top bar
- one sided loop around the hock
- request tail jack
- place strap around the leg above the hock connect to pulley system
- stand aside and use pulley to lift the leg
- place rope through hole, and around the metacarpus encircle bar twice. Stand aside and pull tight.

Describe your method for intravenous regional anaesthesia of the distal hind limb ?

Regional anaesthesia of the distal hind limb
(This block the entire distal hind limb)
Method
- tourniquet rubber tubing
- 21G butterfly catheter or 21G 1.5” needle
- 20ml lignocaine
Method Venous plexus
- ensure surgical prep and restraint
- tourniquet
- inside the second crease midline (about 2.5cm below the fetlock)
- insert needle only quickly full length
- manipulate until you see blood
- attach syringe (no draw back) quickly inject anaesthetic solution
Method dorsal digital vein
- ensure restrain, surgical prep and tourniquet in place
- push down on the dew claws
- palpate vein
- place needle
- inject anaesthesia with no draw back
Takes 10-15mins to take effect.
Tournequet may be safely left in place upto one hour.
When complete slowly release tourniquet over a period of about 10sec, avoids risk of toxication into the systemic circulation.

Identify four sites for venipuncture in the horse ?

Horse; Four sites for venipuncture
- Jugular vein
- Cephalic vein
- Lateral thoracic vein
- Facial venous sinus
Location transverse facial sinus
- place finger and thumb at the lateral and medial canthus of the eye, bring fingers together to a point approximately 2cm below the facial crest.